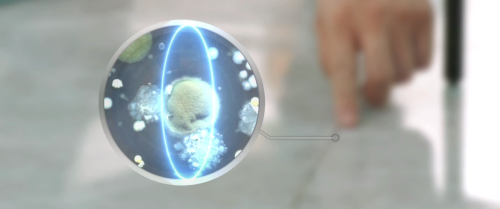
1587126371538376.png 图片1.png

雨虹靓缝剂:精致家居从瓷砖美缝开始!
精致的生活,其实一点都不贵,只要用心,美无处不在。比如,精致的家,可以从瓷砖美缝开始。
别小看这狭窄的几毫米缝隙,若不做美缝,时间长了,瓷砖缝隙容易发黑变脏、滋生细菌,不仅整个地面的颜值会被毁掉,而且还会对家人的健康造成威胁。
而做美缝真的能给你一个精致的家。好的瓷砖美缝产品,具有防水、防霉、耐脏、清理方便等诸多优点,且颜色多种多样,如瓷白、高级灰、钻石金、贵族银等,若搭配得当,就像是给瓷砖化了美美的新妆,穿上了靓丽的新衣,让家居瞬间就能提升好几个档次!
雨虹靓缝剂系列产品具有以下诸多优点,在细节之处彰显精致之美,给家居别样的守护。

1、持久美观:独特釉面,晶莹亮泽;颜色多达16种,色彩丰富、鲜艳。
2、绿色环保:无VOC、无重金属,对人体和环境无危害。
3、防霉抗菌:长效防霉,易拖洗,减少缝隙滋生细菌概率。
4、持久耐污:防水防污,易擦洗。
5、耐磨性强,硬度高:耐磨,不收缩,不开裂,不塌陷。
6、耐高低温、柔韧性强。
7、粘结能力强:可以粘结绝大多数金属与硬质材料。

其实,所有的装修都是为生活服务,风格、品质、视觉效果等等,,最终的目的都是为了满足业主的个人需求或审美需求。瓷砖美缝,给家里的瓷砖化上精致的“妆容”,让每个家,都有主人的样子。